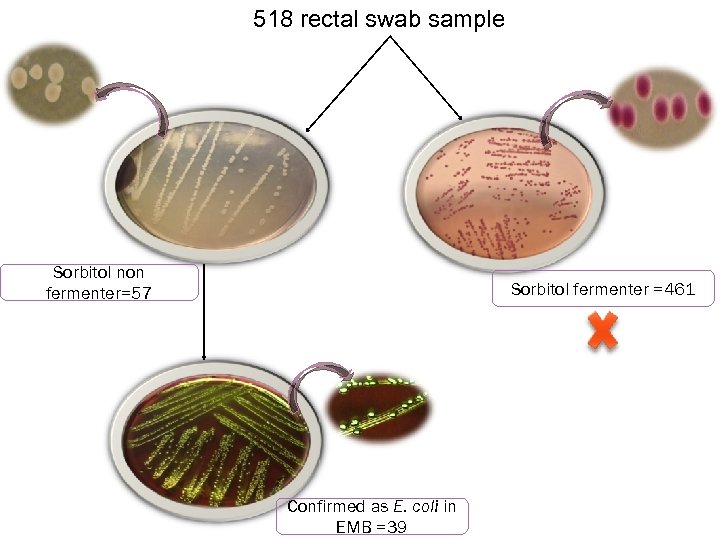

13f60c5443d97e999d54e6ee5d5598c2.ppt
- Количество слайдов: 27

 An Investigation on clonal diversity of Escherichia coli from cattle in smallholdings while using selective media for O 157 strains Md. Zohorul Islam Roll. No. : 0111/03 Reg. No. : 088 Session: 2010 -2011 Department of Microbiology Research Supervisor DR. PARITOSH KUMAR BISWAS Department of Microbiology, CVASU 6 th October, 2012
An Investigation on clonal diversity of Escherichia coli from cattle in smallholdings while using selective media for O 157 strains Md. Zohorul Islam Roll. No. : 0111/03 Reg. No. : 088 Session: 2010 -2011 Department of Microbiology Research Supervisor DR. PARITOSH KUMAR BISWAS Department of Microbiology, CVASU 6 th October, 2012
 Introduction>>> Major categories of pathogenic E. coli Intestinal pathogenic Extra-intestinal pathogenic ØEnterohemorrhagic (EHEC) ØEnterotoxigenic (ETEC) ØUropathogenic (UPEC ) ØEnteropathogenic (EPEC) ØMeningitis associated (MNEC) ØEnteroinvasive (EIEC) ØEnteroaggregative (EAEC) and ØDiffusely adherent (DAEC)
Introduction>>> Major categories of pathogenic E. coli Intestinal pathogenic Extra-intestinal pathogenic ØEnterohemorrhagic (EHEC) ØEnterotoxigenic (ETEC) ØUropathogenic (UPEC ) ØEnteropathogenic (EPEC) ØMeningitis associated (MNEC) ØEnteroinvasive (EIEC) ØEnteroaggregative (EAEC) and ØDiffusely adherent (DAEC)
 Most Important Serotype: EHEC O 157: H 7 Why it is called notorious microbe? - It is an emerging zoonotic pathogen (WHO, 1997) Enter into human food chain It doesn't produce any disease in cattle Hemorrhagic colitis Hemolytic Uremic Syndrome (HUS) Kidney failure Death
Most Important Serotype: EHEC O 157: H 7 Why it is called notorious microbe? - It is an emerging zoonotic pathogen (WHO, 1997) Enter into human food chain It doesn't produce any disease in cattle Hemorrhagic colitis Hemolytic Uremic Syndrome (HUS) Kidney failure Death
 EHEC O 157 virulence factor Genomic marker (gene) Virulence factor Hly Hemolysin Eae Intimin Stx Shiga toxin
EHEC O 157 virulence factor Genomic marker (gene) Virulence factor Hly Hemolysin Eae Intimin Stx Shiga toxin
 Sources of EHEC O 157 Cattle and other ruminant are largest reservoir of EHEC O 157 Food and water contaminated with cattle feces are the major sources for human infection Armstrong et. al. , 1996
Sources of EHEC O 157 Cattle and other ruminant are largest reservoir of EHEC O 157 Food and water contaminated with cattle feces are the major sources for human infection Armstrong et. al. , 1996
 History >>> 2011 Large outbreak in Germany 1993 R, Anderson, 2011 Large western states outbreak, 500 cases and 4 deaths 1985 CDC-MMWR Association of STEC with HUS 1983 1982 Karmali et al. 1985 Description of Shiga toxin First clinical isolation, “Rare E. coli serotype” O’Brien and La. Veck. 1983 Riley et al. 1983
History >>> 2011 Large outbreak in Germany 1993 R, Anderson, 2011 Large western states outbreak, 500 cases and 4 deaths 1985 CDC-MMWR Association of STEC with HUS 1983 1982 Karmali et al. 1985 Description of Shiga toxin First clinical isolation, “Rare E. coli serotype” O’Brien and La. Veck. 1983 Riley et al. 1983
 Objectives >>> Major objectives of this study was • To determine the clonal diversity of probable EHEC O 157 isolates grown on CTSMAC • To estimate the prevalence of probable EHEC O 157 being harbored by the smallholders’ cattle • To phenotypically discriminate the antimicrobial-resistant diversity of the probable EHEC O 157 strains
Objectives >>> Major objectives of this study was • To determine the clonal diversity of probable EHEC O 157 isolates grown on CTSMAC • To estimate the prevalence of probable EHEC O 157 being harbored by the smallholders’ cattle • To phenotypically discriminate the antimicrobial-resistant diversity of the probable EHEC O 157 strains
 Study area Sample collection <<
Study area Sample collection <<
 Results >>> Distribution of EHEC O 157 in smallholders’ cattle No. samples tested No. (%) colorless colony producing isolates in CTSMAC 518 57 (11%) No. (%) probable No. isolates having ≥ 1 virulent gene EHEC O 157 of Stx 1, Stx 2 and hly (%) 39 (7. 5%) 31 (6%) Stx 1= 0. 97% Stx 2=5% hly=3. 1%
Results >>> Distribution of EHEC O 157 in smallholders’ cattle No. samples tested No. (%) colorless colony producing isolates in CTSMAC 518 57 (11%) No. (%) probable No. isolates having ≥ 1 virulent gene EHEC O 157 of Stx 1, Stx 2 and hly (%) 39 (7. 5%) 31 (6%) Stx 1= 0. 97% Stx 2=5% hly=3. 1%
518 rectal swab sample Sorbitol non fermenter=57 Sorbitol fermenter =461 Confirmed as E. coli in EMB =39
518 rectal swab sample Sorbitol non fermenter=57 Sorbitol fermenter =461 Confirmed as E. coli in EMB =39
 Isolate carrying one or more virulent gene = 31 Probable EHEC O 157 = 39 Stx 1= 5 Stx 2 = 26 Hly = 16
Isolate carrying one or more virulent gene = 31 Probable EHEC O 157 = 39 Stx 1= 5 Stx 2 = 26 Hly = 16
 Prevalence of Stx 1 genotype of probable EHEC O 157 in cattle in smallholdings Variable (N) Prevalence % (No. positive ) 95% CI Age Calf (208) 0. 5 (1) 0. 01 – 2. 7 Adult (310) 1. 3 (4) 0. 4 – 3. 3 Local (448) 0. 9 (4) 0. 2 -2. 3 Cross (70) 1. 4 (1) 0. 04 -7. 7 Male (186) 1. 1 (2) 0. 1 – 3. 8 Female (332) 0. 9 (3) 0. 2 – 2. 6 Diseased (90) 1. 1 (1) 0. 03 – 6. 0 Healthy (428) 0. 9 (4) 0. 3 – 2. 4 Yes (64) 1. 6 (1) 0. 04 – 8. 4 No (454) 0. 9 (4) 0. 2 – 2. 2 518 1. 0 (5) 0. 3 – 2. 2 Breed Sex Health status Antibiotic used Total P OR (95% CI) 0. 6527 2. 71 (0. 3 -24. 4) 0. 1373 0. 62 (0. 1 -5. 6) 0. 6589 1. 19 (0. 2 -7. 2) 0. 593 1. 19 (0. 1 -10. 8) 0. 4842 1. 79 (0. 2 -16. 2) - -
Prevalence of Stx 1 genotype of probable EHEC O 157 in cattle in smallholdings Variable (N) Prevalence % (No. positive ) 95% CI Age Calf (208) 0. 5 (1) 0. 01 – 2. 7 Adult (310) 1. 3 (4) 0. 4 – 3. 3 Local (448) 0. 9 (4) 0. 2 -2. 3 Cross (70) 1. 4 (1) 0. 04 -7. 7 Male (186) 1. 1 (2) 0. 1 – 3. 8 Female (332) 0. 9 (3) 0. 2 – 2. 6 Diseased (90) 1. 1 (1) 0. 03 – 6. 0 Healthy (428) 0. 9 (4) 0. 3 – 2. 4 Yes (64) 1. 6 (1) 0. 04 – 8. 4 No (454) 0. 9 (4) 0. 2 – 2. 2 518 1. 0 (5) 0. 3 – 2. 2 Breed Sex Health status Antibiotic used Total P OR (95% CI) 0. 6527 2. 71 (0. 3 -24. 4) 0. 1373 0. 62 (0. 1 -5. 6) 0. 6589 1. 19 (0. 2 -7. 2) 0. 593 1. 19 (0. 1 -10. 8) 0. 4842 1. 79 (0. 2 -16. 2) - -
 Prevalence of Stx 2 genotype of probable EHEC O 157 in cattle in smallholdings Variable (N) Prevalence % (No. positive ) 95% CI Age Calf (208) 3. 4 (7) 1. 4 - 6. 8 Adult (310) 6. 1 (19) 3. 7 - 9. 4 Local (448) 5. 2 (22) 3. 1 - 7. 3 Cross (70) 6. 1 (4) 1. 6 - 14 Male (186) 8. 1 (15) 4. 6 - 13 Female (332) 3. 3 (11) 1. 7 - 5. 9 Diseased (90) 6. 7 (6) 2. 5 - 14 Healthy (428) 4. 7 (20) 2. 9 - 7. 1 Yes (64) 4. 8 (3) 1. 0 - 13 No (454) 5. 1 (23) 3. 2 - 7. 5 518 5 (26) 3. 3 - 7. 3 Breed Sex Health status Antibiotic used Total P OR (95% CI) 0. 2177 1. 87 (0. 8 -4. 5) 0. 5578 0. 85 (0. 3 -2. 6) 0. 0213 2. 56 (1. 2 -5. 7) 0. 2854 1. 46 (0. 6 -3. 7) 1 0. 92 (0. 3 -3. 2) - -
Prevalence of Stx 2 genotype of probable EHEC O 157 in cattle in smallholdings Variable (N) Prevalence % (No. positive ) 95% CI Age Calf (208) 3. 4 (7) 1. 4 - 6. 8 Adult (310) 6. 1 (19) 3. 7 - 9. 4 Local (448) 5. 2 (22) 3. 1 - 7. 3 Cross (70) 6. 1 (4) 1. 6 - 14 Male (186) 8. 1 (15) 4. 6 - 13 Female (332) 3. 3 (11) 1. 7 - 5. 9 Diseased (90) 6. 7 (6) 2. 5 - 14 Healthy (428) 4. 7 (20) 2. 9 - 7. 1 Yes (64) 4. 8 (3) 1. 0 - 13 No (454) 5. 1 (23) 3. 2 - 7. 5 518 5 (26) 3. 3 - 7. 3 Breed Sex Health status Antibiotic used Total P OR (95% CI) 0. 2177 1. 87 (0. 8 -4. 5) 0. 5578 0. 85 (0. 3 -2. 6) 0. 0213 2. 56 (1. 2 -5. 7) 0. 2854 1. 46 (0. 6 -3. 7) 1 0. 92 (0. 3 -3. 2) - -
 Prevalence of hly genotype of probable EHEC O 157 in cattle in smallholdings Variable (N) Prevalence % (No. positive ) 95% CI Age Calf (208) 1. 9 (4) 0. 5 – 4. 9 Adult (310) 3. 9 (12) 2. 0 – 6. 7 Local (448) 2. 9 (13) 1. 6 – 4. 9 Cross (70) 4. 3 (3) 0. 9 – 12 Male (186) 3. 8 (7) 1. 5 – 7. 6 Female (332) 2. 7 (9) 1. 3 – 5. 1 Health status Diseased (90) 5. 6 (5) 1. 8 – 12. 5 Healthy (428) 2. 6 (11) 1. 3 – 4. 6 Antibiotic uesed Yes (64) 7. 8 (5) 2. 6 – 17. 3 No (454) 2. 4 (11) Total 518 3. 1 (16) Breed Sex P OR (95% CI) 0. 301 2. 05 (0. 7 -6. 5) 0. 4645 0. 67 (0. 2 -2. 4) 0. 5981 1. 4 (0. 5 -3. 8) 0. 1716 2. 23 (0. 8 -6. 6) 1. 2 – 4. 3 0. 0364 3. 41 (1. 2 -10. 2) 1. 8 – 5 - -
Prevalence of hly genotype of probable EHEC O 157 in cattle in smallholdings Variable (N) Prevalence % (No. positive ) 95% CI Age Calf (208) 1. 9 (4) 0. 5 – 4. 9 Adult (310) 3. 9 (12) 2. 0 – 6. 7 Local (448) 2. 9 (13) 1. 6 – 4. 9 Cross (70) 4. 3 (3) 0. 9 – 12 Male (186) 3. 8 (7) 1. 5 – 7. 6 Female (332) 2. 7 (9) 1. 3 – 5. 1 Health status Diseased (90) 5. 6 (5) 1. 8 – 12. 5 Healthy (428) 2. 6 (11) 1. 3 – 4. 6 Antibiotic uesed Yes (64) 7. 8 (5) 2. 6 – 17. 3 No (454) 2. 4 (11) Total 518 3. 1 (16) Breed Sex P OR (95% CI) 0. 301 2. 05 (0. 7 -6. 5) 0. 4645 0. 67 (0. 2 -2. 4) 0. 5981 1. 4 (0. 5 -3. 8) 0. 1716 2. 23 (0. 8 -6. 6) 1. 2 – 4. 3 0. 0364 3. 41 (1. 2 -10. 2) 1. 8 – 5 - -
 Diversity among the isolates lacking any virulent gene of Stx 1, Stx 2 and hly Seven isolates was tested for 7 housekeeping gene of E. coli Seven such isolates was tested for clonal diversity by PFGE These isolates was also tested for plasmid profile
Diversity among the isolates lacking any virulent gene of Stx 1, Stx 2 and hly Seven isolates was tested for 7 housekeeping gene of E. coli Seven such isolates was tested for clonal diversity by PFGE These isolates was also tested for plasmid profile
 Detection of 7 housekeeping gene probable EHEC O 157 isolates, that lacked any of the 3 virulent genes, possessed all the seven house keeping genes - adk, fum. C, gyr. B, icd, mdh, pur. A and rec. A It reconfirms their fidelity as E. coli at the molecular level
Detection of 7 housekeeping gene probable EHEC O 157 isolates, that lacked any of the 3 virulent genes, possessed all the seven house keeping genes - adk, fum. C, gyr. B, icd, mdh, pur. A and rec. A It reconfirms their fidelity as E. coli at the molecular level
 Gel Image of housekeeping gene of E. coli Gyrb-911 bp rec. A-780 bp Icd-878 bp fum. C- 806 bp
Gel Image of housekeeping gene of E. coli Gyrb-911 bp rec. A-780 bp Icd-878 bp fum. C- 806 bp
 Plasmid profiling All the seven isolates had a >54. 2 kb size plasmid Six isolates contained ≥ 1<3 plasmids Four of the isolates contained very large plasmid of 147 kb size
Plasmid profiling All the seven isolates had a >54. 2 kb size plasmid Six isolates contained ≥ 1<3 plasmids Four of the isolates contained very large plasmid of 147 kb size
 PFGE findings Except for two, all other E. coli isolates are genetically diverse, displaying six different band patterns
PFGE findings Except for two, all other E. coli isolates are genetically diverse, displaying six different band patterns
 Phenotypic diversity based on Antimicrobial resistance patterns Frequencies of Stx 1, Stx 2 and hly genotypic isolates resistant to the antimicrobials Antimicrobial No. resistant isolates (%) Stx 1 (n=5) Stx 2 (n=26) hly (n=16) AML 1 (20%) 8 (31%) 5 (31%) CRO 1 (20%) 2 (7%) 2 (13%) NA 1 (20%) 4 (15%) 2 (13%) CIP 1 (20%) 2 (7%) 1 (6%) TE 1 (20%) 15 (58%) 3 (19%) AMP 2 (40%) 9 (35%) 5 (31%) P 5 (100%) 26 (100%) 16 (100%) DOC 1 (20%) 3 (12%) 1 (6%) SXT 3 (60%) 14 (54%) 7 (44%) CN 2 (40%) 5 (19%) 3 (19%) C 0 (0%)
Phenotypic diversity based on Antimicrobial resistance patterns Frequencies of Stx 1, Stx 2 and hly genotypic isolates resistant to the antimicrobials Antimicrobial No. resistant isolates (%) Stx 1 (n=5) Stx 2 (n=26) hly (n=16) AML 1 (20%) 8 (31%) 5 (31%) CRO 1 (20%) 2 (7%) 2 (13%) NA 1 (20%) 4 (15%) 2 (13%) CIP 1 (20%) 2 (7%) 1 (6%) TE 1 (20%) 15 (58%) 3 (19%) AMP 2 (40%) 9 (35%) 5 (31%) P 5 (100%) 26 (100%) 16 (100%) DOC 1 (20%) 3 (12%) 1 (6%) SXT 3 (60%) 14 (54%) 7 (44%) CN 2 (40%) 5 (19%) 3 (19%) C 0 (0%)
 Overall antimicrobial resistance pattern 88%, 84% and 82% isolates were sensitive to chloramphenicle, gentamicine and ciprofloxacin, respectively 100% isolates were resistant to penicillin, and 53% to trimethoprim-sulfomethoxazole.
Overall antimicrobial resistance pattern 88%, 84% and 82% isolates were sensitive to chloramphenicle, gentamicine and ciprofloxacin, respectively 100% isolates were resistant to penicillin, and 53% to trimethoprim-sulfomethoxazole.
 Multi drug resistant pattern About 60% isolates carrying all the three EHEC O 157 virulent genes were resistant to ≥ 2 antimicrobials, among them one isolate was resistant to six antimicrobials Isolates having no virulent gene, but harboring 54. 2 kb sized plasmid were resistant to tetracycline, salfomethoxazole, ampicillin and amoxicillin
Multi drug resistant pattern About 60% isolates carrying all the three EHEC O 157 virulent genes were resistant to ≥ 2 antimicrobials, among them one isolate was resistant to six antimicrobials Isolates having no virulent gene, but harboring 54. 2 kb sized plasmid were resistant to tetracycline, salfomethoxazole, ampicillin and amoxicillin
 Conclusion Ø Based on the possession of three virulent genes – Stx 1, Stx 2 and hly the strains of EHEC O 157 isolated from this study are not clonal, but diverse Ø 31 strains had ≥ 1 of these three genes; among them 28 were shiga toxin producing because they harbor either Stx 1 or Stx 2 gene or the both. ØBy PFGE assay and plasmid profiling of the 7 isolates lacking any of the mentioned three virulent genes, 6 genotypes were identified, suggesting that these isolates were not clonally related either except for two. ØThe antimicrobial resistance profiles of the colorless colony producing isolates to the 11 antimicrobials tested also varied.
Conclusion Ø Based on the possession of three virulent genes – Stx 1, Stx 2 and hly the strains of EHEC O 157 isolated from this study are not clonal, but diverse Ø 31 strains had ≥ 1 of these three genes; among them 28 were shiga toxin producing because they harbor either Stx 1 or Stx 2 gene or the both. ØBy PFGE assay and plasmid profiling of the 7 isolates lacking any of the mentioned three virulent genes, 6 genotypes were identified, suggesting that these isolates were not clonally related either except for two. ØThe antimicrobial resistance profiles of the colorless colony producing isolates to the 11 antimicrobials tested also varied.
 Conclusion ØBased on colorless colonies on a CT-SMAC agar plate we couldn’t predict it as EHEC O 157 unless other confirmatory tests are applied, such as identification of the presence of at least one virulent gene by a PCR assay.
Conclusion ØBased on colorless colonies on a CT-SMAC agar plate we couldn’t predict it as EHEC O 157 unless other confirmatory tests are applied, such as identification of the presence of at least one virulent gene by a PCR assay.
 Acknowledgements My Research Supervisor & RFLDC PRTC Jens P. Christensen, Department of Veterinary Disease Biology, Copenhagen University, Denmark Department of Microbiology, CVASU
Acknowledgements My Research Supervisor & RFLDC PRTC Jens P. Christensen, Department of Veterinary Disease Biology, Copenhagen University, Denmark Department of Microbiology, CVASU
 THANK YOU ALL
THANK YOU ALL


